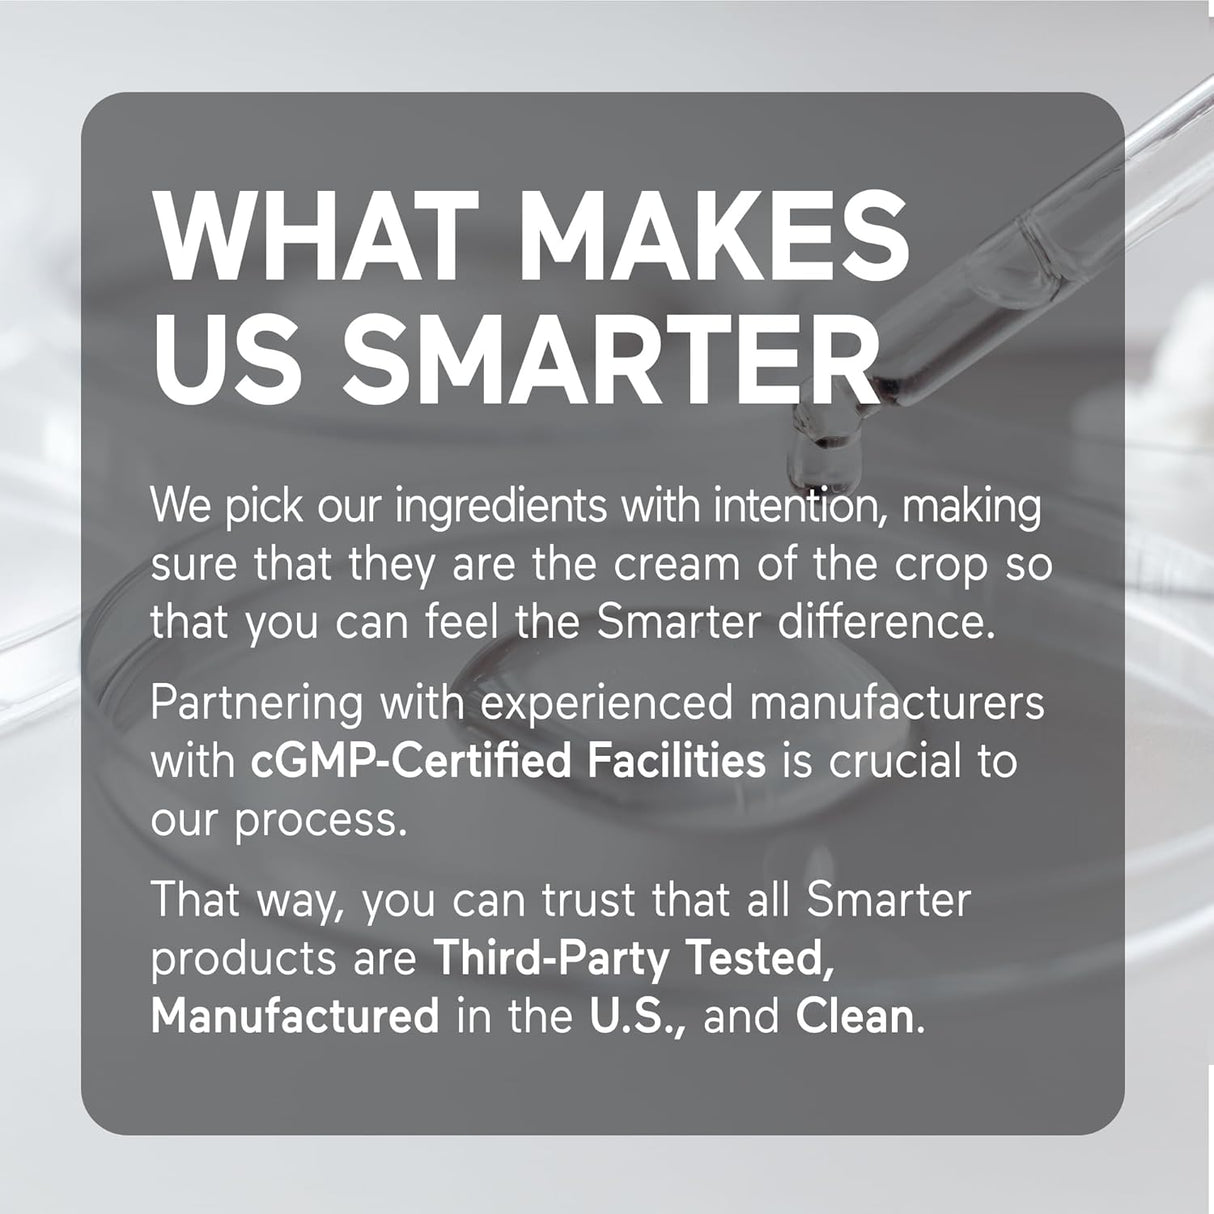
SmartNutrition Vitamina D3 K2 Vegana 60 cápsulas

SmartNutrition Vitamina D3 K2 Vegana 60 cápsulas
SmartNutrition Vitamina D3 K2 Vegana 60 cápsulas está agotado y se enviará tan pronto como vuelva a estar disponible.
No se ha podido cargar la disponibilidad de recogida
GARANTIA
GARANTIA
El usuario podrá solicitar la devolución o cambio de los productos adquiridos. Para ello, el trámite deberá realizarse directamente a través del área de compras de Usaloya.
Correo: customerservice@anicamenterprises.com
Teléfono: 314 813 0486
Ubicación: Transversal 93 N° 53-32, Parque Empresarial Dorado, Bodega 13, Bogotá
- Colombia.
TIEMPOS DE ENVÍO
TIEMPOS DE ENVÍO
Los productos serán entregados dentro de los diez (10) días hábiles siguientes a la aceptación de la solicitud del usuario, excepto en el caso de ciertos productos específicos cuyo tiempo de entrega sea superior. En tales casos, el usuario será informado una vez que Usaloya haya realizado la compra de dichos productos. El usuario/consumidor podrá cancelar la orden dentro de las doce (12) horas siguientes a la recepción de esta notificación.